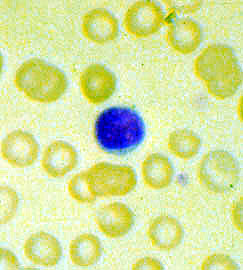

Microcytic, hypochromic red blood cells, Peripheral blood smear
Click picture to enlarge. Close window to return
The RBCs are small in size, MCV 80. (Compare the size of the RBCs with the lymphocyte). The red cells are also hypochromic, displaying an enlarged zone of central pallor. Hypochromasia represents a distrurbance in hemoglobin synthesis. Microcytic hypochromic anemia is observed in classical cases of iron deficiency anemia and thalassemia.